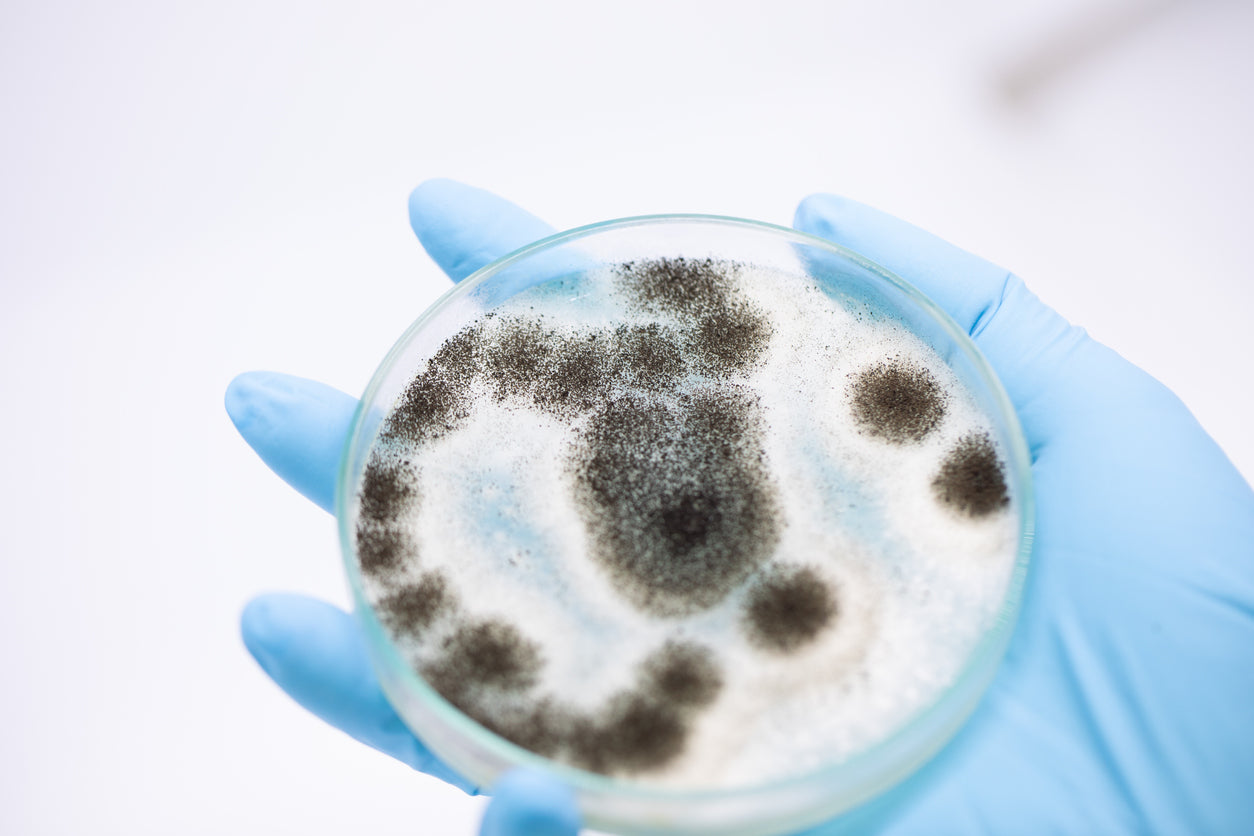

Mold sensitivity is a somewhat controversial diagnosis in the medical community. While we have ample scientific evidence that mold spores may trigger allergy and asthma symptoms, some people report experiencing a wider range of symptoms caused by mold exposure. These symptoms are often psychological or behavioral in nature, do not have any clearly identifiable cause and cannot be diagnosed with medical testing.
Similar to sick building syndrome (SBS), mold sensitivity is a little-understood condition associated with a broad variety of reported symptoms. It is even sometimes listed as one of the potential causes of SBS symptoms. While there is a lack of scientific evidence to explain the biological mechanisms/functions that cause mold sensitivity symptoms, some people still report being affected by this condition. Below, we take a look at what we know about mold allergies and mold sensitivity so that you can form your own conclusions about the condition.
What do mold allergy symptoms feel like?
Mold is a fungi that releases microscopic airborne spores. Some molds are commonly found in households and may release spores and other particles into the air. If you have a mold allergy, it means that your body is sensitive to molds. When you breathe in airborne mold particles, your immune system may react and start trying to fight off the mold. The antibodies produced, including histamine, when your body tries to fight off the mold can cause hay fever-type symptoms, including:
- Sneezing
- Coughing
- Itchy, watery eyes
- Runny nose or nasal congestion
- Throat irritation
- Skin rash
An allergic reaction to mold may happen immediately after exposure, or it may be delayed. Mold allergy symptoms and their severity will vary from person to person, depending on the type and severity of his or her allergy. For example, some people only experience mold allergy symptoms during certain weather conditions. Additionally, outdoor molds may only cause allergic reactions during certain seasons, but indoor mold, such as black mold, can cause reactions all year round.
Note: Where you live may affect your exposure to outdoor mold.
How does mold exposure affect asthma and existing allergies?
Once you have an allergic reaction to mold, no matter how mild, you may become sensitized to mold spores as an allergen. Long-term exposure to mold may cause mold-related allergy and asthma symptoms to become worse over time. Exposure to mold or dampness may even cause people to develop asthma, according to the CDC.
Mold exposure is a known asthma trigger and may cause inflammation and tightness in the respiratory system as well as mucus in the airways. If you have asthma and an allergy to mold, you may notice that exposure to mold spores may trigger asthma symptoms such as shortness of breath, chest tightness, wheezing and coughing. In more severe cases, exposure to mold spores may cause an asthma attack.
What do we know about mold sensitivity?
The term ”mold sensitivity” is broadly used to refer to any chronic non-allergic response to mold exposure. Mold sensitivity is not understood nearly as well as mold allergies because the condition is associated with an undefined range of symptoms that have no measurable cause. Some people report experiencing a wide array of symptoms that they believe to be caused by mold sensitivity. These symptoms include anxiety, cognitive issues, depression and insomnia, as well as different types of physical pain. Because mold sensitivity cannot be measured, there is no observable link between the condition and its associated symptoms.
Unfortunately, Western medicine has no answer for those who believe they are affected by mold sensitivity, also referred to as vulnerability to mold toxicity. Unlike mold allergies that can be diagnosed with a skin test or allergen-specific immunoglobulin blood test, there is no test that can diagnose this issue, and there is a lack of scientific research to back up information about the condition. The EPA states that mold-related symptoms other than allergic reactions and irritation by spores are not commonly reported.
A study by the Medical College of Wisconsin found that some people did experience symptoms caused by a toxic, rather than an allergic, reaction to mold exposure, though cases of this were rare. Study authors suggested that non-allergic reactions to mold exposure may be caused by other substances produced by the fungi as they metabolize food, but that more research is needed to understand fully how and why these non-allergic reactions occur (Edmondson, et. al, 2005).
How to prevent mold exposure in your home
Mold exposure may adversely affect your health, even if you do not have asthma or a mold allergy. By keeping your home clean and free of visible mold, you can help reduce your daily exposure to the airborne allergen. Mold can start to grow when mold spores land on any wet surface in your home, and signs of mold growth include water stains and an earthy, musty odor.
You can help prevent mold growth in your home by:
- Eliminating sources of dampness — Basements, bathrooms, laundry rooms and window sills can be especially prone to dampness. If you check these places regularly for moisture, you can eliminate any excess dampness before mold has a chance to grow.
- Using a dehumidifier — By keeping the relative humidity of your home under 50%, you can keep your space from becoming humid enough to support mold and mildew growth.
- Using an air conditioner with HEPA attachment — An air conditioner can help increase your indoor airflow, and a HEPA filter can trap mold spores and keep them from circulating around your home. However, for this method to be effective, you should change your HEPA filter regularly to prevent the accumulation and growth of mold on the filter itself.
- Increasing ventilation — Using exhaust fans and opening windows can help you increase ventilation and decrease the mold spore concentration in your home. This is especially important in areas that are regularly damp, such as bathrooms and cooking areas.
- Using an air purifier — Many air cleaning technologies claim to address airborne mold spores, though effectiveness can vary significantly. Some traditional technologies like HEPA air purifiers leave the possibility that mold can multiply on the filter surface over time; filters should be replaced frequently to prevent this. The Molekule PECO air purifier, our solution discussed in the final paragraph, is the only air purifier technology that effectively destroys mold particles, instead of simply trapping them on filters.
While the ideal situation is to prevent mold growth in the first place, you cannot always avoid stumbling upon a surprise patch of mold in your home. If this happens to you, try to eliminate the source of excess moisture and clean up the mold as quickly as possible using detergent and water, according to the EPA. You may have to throw away any porous or absorbent materials that have been become moldy. When you are finished, you should make sure that the entire area, including all furniture and other objects that have come into contact with the mold, is completely dry.
Our air quality solution for mold
Though more research is needed to support mold sensitivity in the scientific community, prolonged exposure to indoor mold in your home is unhealthy for everyone, regardless if you have a mold allergy or suspect a mold sensitivity. After taking steps to prevent visible mold growth, mold spores can be addressed by an air purifier. Our solution, the Molekule PECO technology, was developed over 20 years to address many of the common concerns of indoor air quality, including airborne mold. In addition to common indoor air pollutants like VOCs, pollen and dust mites, PECO technology is the only one that can reliably destroy mold particles, including fragments, spores and mycotoxins. Keeping airborne mold to a minimum can help you and your family breathe clean air.